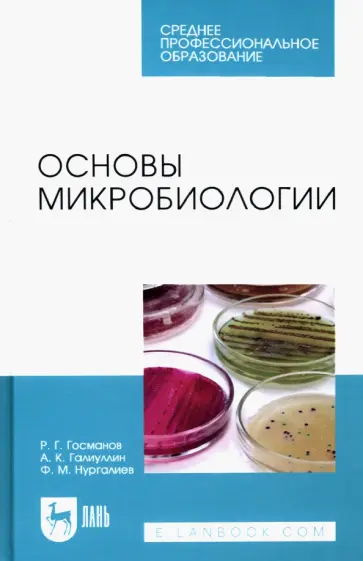
Госманов, Галиуллин - Основы микробиологии. Учебник для СПО Госманов, Галиуллин - Основы микробиологии. Учебник для СПО обложка книги

Госманов Рауис Госманович
Авторы /
Госманов Рауис ГосмановичФильтры
Найдено
Сбросить
Отзывов пока нет. Поделитесь впечатлениями
Вы можете стать одним из первых, кто оставил отзыв об авторе.
Мы всегда рады честным, конструктивным рецензиям.
Внимание!
Если Вы обнаружили ошибку на персональной странице автора "Госманов Рауис Госманович", пишите об этом в сообщении об ошибке. Спасибо!
Если Вы обнаружили ошибку на персональной странице автора "Госманов Рауис Госманович", пишите об этом в сообщении об ошибке. Спасибо!
Ваша корзина невероятно пуста.
Не знаете, что почитать?
Лабиринт.Сейчас
Не знаете, что почитать?
Здесь наша редакция собирает для вас
лучшие книги и важные события.
Главные книги
А тут читатели выбирают все самое любимое.
Примем заказ, ответим на все вопросы
Укажите регион, чтобы мы точнее рассчитали условия доставки
Например:
Москва,
Санкт-Петербург,
Новосибирск,
Екатеринбург,
Нижний Новгород,
Краснодар,
Челябинск,
Кемерово,
Тюмень,
Красноярск,
Казань,
Пермь,
Ростов-на-Дону,
Самара,
Омск